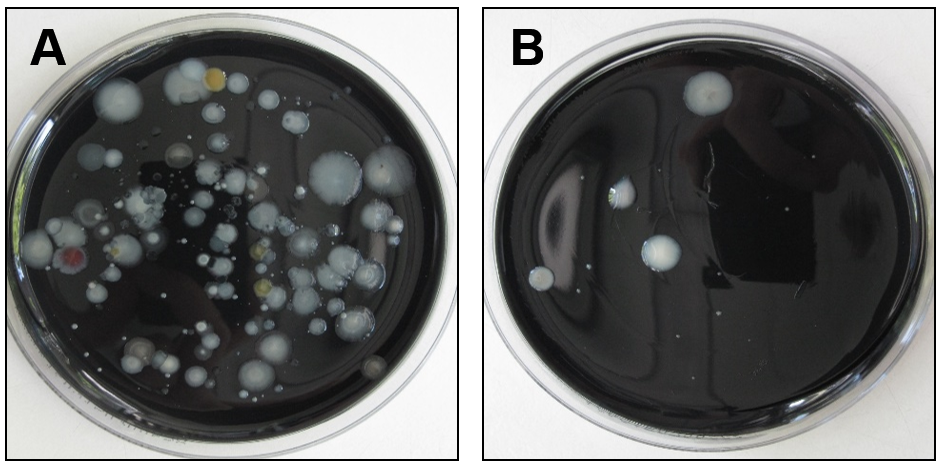
Die Abbildung zeigt zwei Kulturplatten, auf die recyceltes Wasser aus einer Fahrzeugwaschanlage ausplattiert wurde. Die Platten wurden für 7 Tage bei 36 °C inkubiert. Auf Platte A wurde die Probe direkt ausplattiert; hier sind viele Kolonien unterschiedlicher Mikroorganismen zu sehen. Platte A ist stark überwachsen und ein Nachweis von Legionellen schwierig. Platte B zeigt nur wenige Kolonien. Hier wurde ein Großteil der in der Wasserprobe vorkommenden Begleitflora erfolgreich durch eine Behandlung der Probe mit Wärme von 50 °C über 30 Minuten abgetötet.

- Startseite >>
- Gesundheit >>
- Hygiene >>
- Wasserhygiene >>
- Legionellen
Legionellen in Fahrzeugwaschanlagen
Abstract
In einem vom Bayerischen Staatsministerium für Umwelt und Verbraucherschutz (StMUV) geförderten Projekt untersucht das LGL Fahrzeugwaschanlagen auf das Vorkommen von Legionellen im Wasser und dem von den Anlagen produzierten Aerosol (luftgetragene Tröpfchen). Der Fokus liegt dabei auf dem Arbeitsplatz, da die Beschäftigten dort wiederholt und länger exponiert sind, wenn sie am Waschprozess beteiligt sind oder ihr Arbeitsplatz in der direkten Umgebung liegt.
Für die Probenbearbeitung und Analyse von Legionellen kommen etablierte Nachweismethoden wie die Kulturmethode (sogenannter „Goldstandard“) zum Einsatz. Weiterhin werden moderne molekularbiologische Nachweisverfahren in diesem Projekt an den Wasser- und Aerosolproben aus Fahrzeugwaschanlagen im Vergleich zum Goldstandard eingesetzt.
Langfristiges Ziel ist es, zukünftig eine Risikobewertung solcher Anlagen im Hinblick auf eine Legionelleninfektion von Beschäftigten zu ermöglichen.
Einleitung
Legionellen sind weit verbreitete Bakterien in der natürlichen Umwelt, die sich hauptsächlich in stehendem Wasser zwischen 25 und 60 °C vermehren. Sie können Infektionskrankheiten, sogenannte Legionellosen, auslösen. Für 90 % der nachgewiesenen Erkrankungen ist die Art Legionella pneumophila verantwortlich. Legionellosen nehmen in vielen Fällen einen milden klinischen Verlauf, auch als Pontiac Fieber bezeichnet. Bei der sogenannten Legionärskrankheit liegt bei hospitalisierten Patienten die Sterblichkeit jedoch bei etwa 10 %. Die Legionärskrankheit ist in Deutschland für ungefähr 4 % der ambulant erworbenen Lungenentzündungen verantwortlich. In künstlichen wasserführenden Systemen können sich Legionellen vermehren und zu Infektionen führen, wenn die Legionellen aerosolisiert und inhaliert werden.
Fahrzeugwaschanlagen erzeugen im Waschprozess sehr viel Aerosol. Zusätzlich erfolgt die Verwendung von recyceltem Wasser, das teilweise sehr lange steht und/oder erwärmt wird. Die aufgezählten Bedingungen können zu einer starken Vermehrung von Legionellen führen, welche über die Anlagen anschließend als Bioaerosol (luftgetragene Mikroorganismen) in der Luft verteilt werden können. Aus diesen Gründen sind Fahrzeugwaschanlagen als potentielle Quelle für Legionellosen zu betrachten. Beschäftigte sind möglicherweise besonders gefährdet, da sie länger und wiederholt exponiert sind, wenn sie am Waschprozess beteiligt sind oder ihr Arbeitsplatz in der direkten Umgebung liegt.
Um das Auftreten von Legionellen-haltigen Aerosolen an einem solchen Arbeitsplatz zukünftig besser abschätzen zu können, werden Untersuchungen für Legionella Spezies und die klinisch besonders relevante Art Legionella pneumophila durchgeführt. Für die Untersuchungen werden Wasser- und Luftproben von Fahrzeugwaschanlagen genommen und im Labor mit der Kulturmethode (Nachweis auf Nährböden) und modernen molekularbiologischen Nachweismethoden wie der quantitativen Polymerase-Kettenreaktion mit zusätzlichem Nachweis auf Lebensfähigkeit (Lebensfähigkeits-qPCR) untersucht.
Vorgehen und Ergebnisse
Bisher erfolgten in dem Projekt Untersuchungen von Wasser- und Luftproben aus 14 verschiedenen Fahrzeugwaschanlagen in Oberbayern mit Hilfe der Kulturmethode, der qPCR und Lebensfähigkeits-qPCR. Zur Reduzierung störender Begleitflora wurde die Kulturmethode für die Wasserproben unter Anwendung einer Wärme- und Säurebehandlung durchgeführt
Abbildung von zwei Kulturplatten
Die Abbildung zeigt das Untersuchungsergebnis der Kulturmethode. Gezeigt sind zwei Kulturplatten, auf die recyceltes Wasser aus einer Fahrzeugwaschanlage ausplattiert wurde. Die Platten wurden für 7 Tage bei 36 °C inkubiert. Auf Platte A wurde die Probe direkt ausplattiert; hier sind viele Kolonien unterschiedlicher Mikroorganismen zu sehen. Platte A ist stark überwachsen und ein Nachweis von Legionellen schwierig. Platte B zeigt nur wenige Kolonien. Hier wurde ein Großteil der in der Wasserprobe vorkommenden Begleitflora erfolgreich durch eine Behandlung der Probe mit Wärme von 50 °C über 30 Minuten abgetötet.
Wie in der folgenden Tabelle dargestellt, waren mit der Lebensfähigkeits-qPCR als molekularbiologische Methode 100% der Wasserproben positiv für Legionella Spezies, mit der Kulturmethode dagegen nur 7%. L. pneumophila wurde nur in den Wasserproben einer Anlage nachgewiesen (7% bzw. 3%).
Von den Luftproben waren 80% der Arbeitsplatz-Proben und 100% der Proben aus der Waschstraße mittels Lebensfähigkeits-PCR positiv für Legionella Spezies. Die Luftproben waren jedoch negativ für L. pneumophila.
Die in der Regel 10 Tage dauernde Untersuchungszeit bei Anwendung der Kulturmethode kann mit Hilfe der modernen molekularbiologischen Methoden (hier PCR) auf einen Tag reduziert werden.
| Auf Legionella Spezies positiv getestete Proben | Auf L. pneumophila positiv getestete Proben | |||
|---|---|---|---|---|
| Lebensfähig-keits-qPCR | Kultur-methode | Lebensfähig-keits-qPCR | Kultur-methode | |
| Recyceltes Wasser | 100% | 7% | 7% | 3% |
| Luft - Arbeitsplatz | 90% | 0% | 0% | 0% |
| Luft - Waschstraße | 100% | 0% | 0% | 0% |
Fazit
Bei den komplexen Proben aus Fahrzeugwaschanlagen ist mit der Kulturmethode (Goldstandard) von einer hohen Untererfassung von Legionellen auszugehen. Zum einen führt die hohe Belastung der Proben mit weiteren Mikroorganismen (Begleitflora) zu einer Unterdrückung der vergleichsweise langsam wachsenden Legionellen. Zum anderen ist kein Nachweis von nicht-kultivierbaren und in Wirtszellen (Amoeben) lebenden Legionellen möglich.
Die hier eingesetzte Lebensfähigkeits-qPCR befindet sich noch in der Entwicklung. Mit dieser sensiblen molekularen Methode gelang es in allen Wasserproben der Fahrzeugwaschanlagen Hinweise auf die in der Umwelt weit verbreiteten Legionella Spezies zu finden. Auf die häufig mit Krankheiten assoziierten L. pneumophila fand sich nur in einer Anlage im recycelten Wasser Hinweise, nicht jedoch in deren Luftproben in der Waschstraße und am Arbeitsplatz.
Ausblick
Im Projektverlauf erfolgen Untersuchungen an weiteren Anlagen, um die Belastbarkeit der bisherigen Befunde zu ermitteln und eine Risikoabschätzung vorzunehmen. Daraus soll abgeleitet werden, inwiefern es erforderlich ist, aus Gründen der Vorsorge zum Schutz von Nutzern und Arbeitnehmern, Maßnahmen für die Anlagen zu empfehlen.
Mehr zu diesem Thema
Allgemeine Informationen zum Thema
Weitere LGL-Artikel
- Legionellen - die am häufigsten gestellten Fragen
- Infektionsgefährdung durch Einatmen von Legionellen-haltigem Aerosol
- Analyse der bakteriellen Aerosolkontamination am Arbeitsplatz in Fahrzeugwaschanlagen


